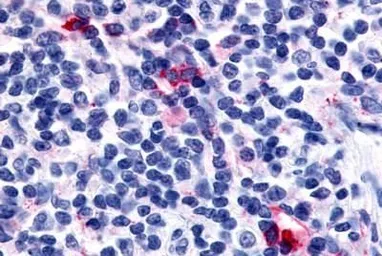

CXCR6 antibody
Cat. No. GTX77935
Cat. No. GTX77935
-
HostRabbit
-
ClonalityPolyclonal
-
IsotypeIgG
-
ApplicationsIHC-P
-
ReactivityHuman, Monkey